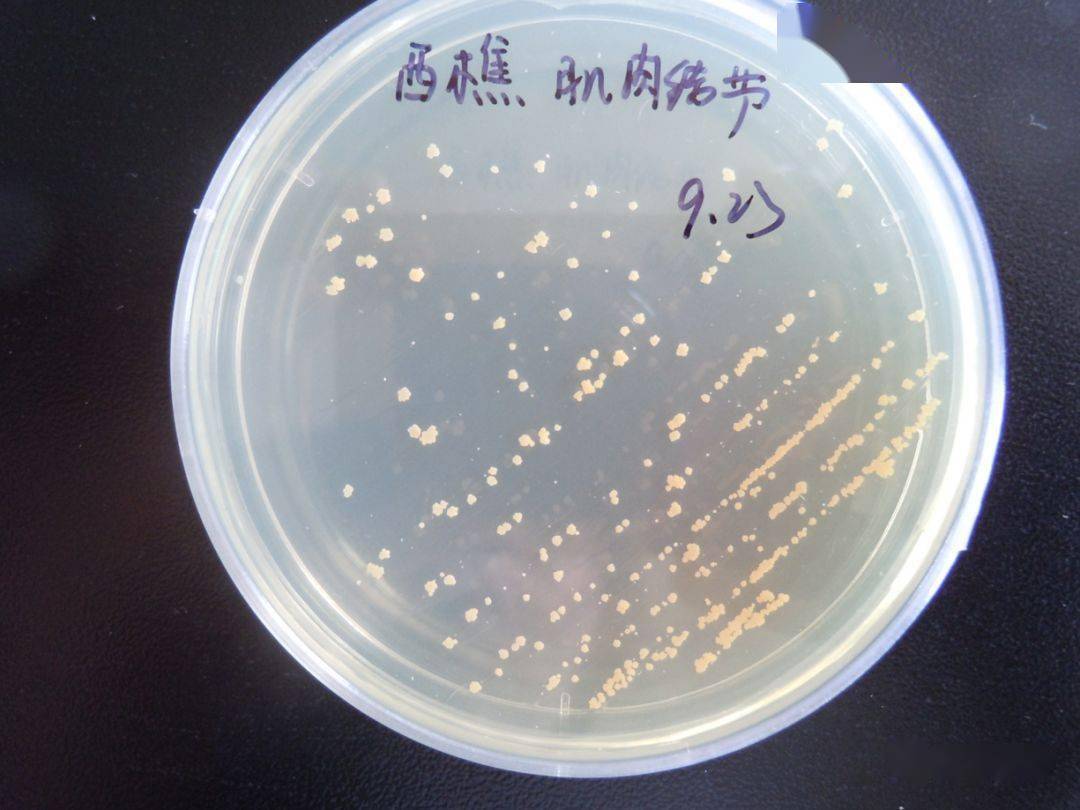
在普通培养基上面分离诺卡氏菌,常温条件下(25-28℃)需要10天以上

诺卡菌菌落图片

一种北极拟诺卡氏菌及其发酵产物优化方法与流程
图片尺寸1000x955
诺卡菌 - 感染专业讨论版 -丁香园论坛
图片尺寸426x568
诺卡菌
图片尺寸476x436
【图文讲解】容易被忽略的诺卡菌
图片尺寸1080x1440
【图文讲解】容易被忽略的诺卡菌
图片尺寸1080x1440
一例萜烯诺卡菌肺炎的实验室诊断
图片尺寸668x670
新冠患者合并圣乔治诺卡菌感染1例_腾讯新闻
图片尺寸1000x981
检验科成功协助临床医生诊断全身播散性诺卡菌感染一例
图片尺寸1080x1440
俊豪老师讲肺病之诺卡菌肺炎的前世今生
图片尺寸1080x1440
分享广西贺州市人医 梁老师精美图片,新澙诺卡菌一例,革兰 - 抖音
图片尺寸1920x1440
诺卡氏菌属细菌插图
图片尺寸1200x800
一例皮疽诺卡菌播散性感染病例分享
图片尺寸447x526
千丝万缕"诺卡君",咳咳痰痰"诺卡菌"
图片尺寸866x708
从原始平板上转种出来的诺卡菌菌落,48h革兰阳性细长杆菌 抗酸(-) 弱
图片尺寸779x584
诺卡氏菌在农业上的应用
图片尺寸462x350
太阳鱼诺卡氏菌病的诊断和防治
图片尺寸482x414
诺卡菌
图片尺寸795x540
在普通培养基上面分离诺卡氏菌,常温条件下(25-28℃)需要10天以上
图片尺寸1080x810
病例分享-萜烯诺卡菌(nocardia terpenica)?
图片尺寸2789x2734
千丝万缕"诺卡君",咳咳痰痰"诺卡菌"
图片尺寸960x746